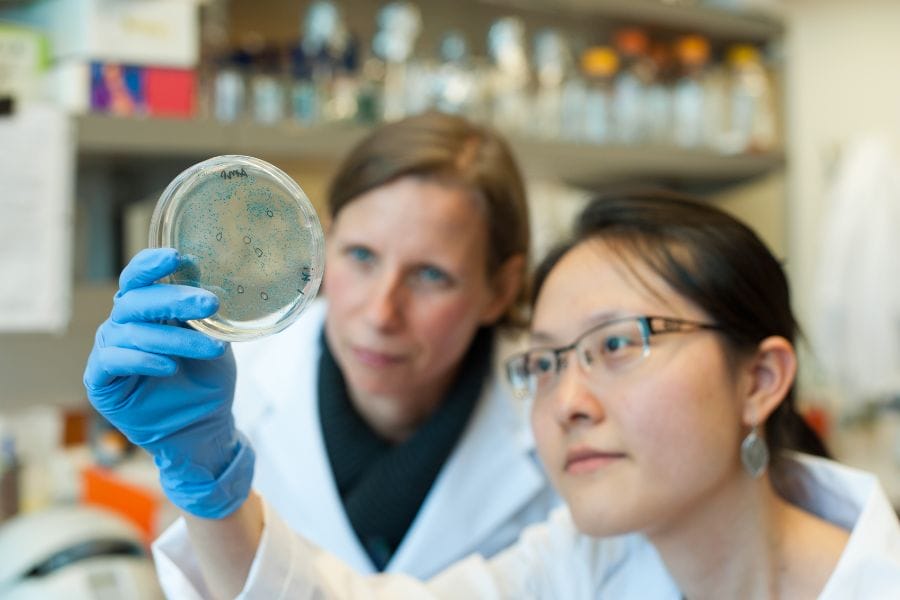

Research Themes
Research Themes Facilitate and Support Research
Scientists and clinicians at BC Children’s Hospital Research Institute (BCCHR) engage in research across many different fields to save and improve the lives of children. In order to build community and optimize resources and administrative support, all our researchers are members of one of four research themes: Brain, Behaviour & Development, Childhood Diseases, Evidence to Innovation, and Healthy Starts.
FUNDING & EVENTS
Each theme offers annual research funding opportunities, as well as regular events, seminars, cross-theme activities and other networking opportunities that bring researchers together to learn about and discuss their research. Learn more about the funding opportunities and events for each theme by clicking on the links below. A BCCHR/PHSA/UBC login is required to access this information on our intranet, ResearchHub.
- Funding opportunities: Brain, Behaviour & Development, Childhood Diseases, Evidence to Innovation, and Healthy Starts
- Events: Brain, Behaviour & Development, Childhood Diseases, Evidence to Innovation, and Healthy Starts
Brain, Behaviour & Development
The Brain, Behaviour & Development (BB&D) Theme brings together neuroscience, mental health, and child development researchers through basic, clinical, population, and public health research. We work to improve care for children with complex medical, physical, developmental, and mental health needs.
LEARN MOREChildhood Diseases
The Childhood Diseases Theme focuses on studying childhood diseases and disorders. We’re dedicated to discovering how the body responds to illness, with a specific focus on understanding the mechanisms of health versus disease, as well as identifying and testing new diagnostic and therapeutic approaches.
LEARN MOREEvidence to Innovation
The Evidence to Innovation (E2i) Theme is working to develop new health-care technologies, improve patient care, advance the safe and effective use of drugs, develop new methods of health data analytics, and shift health system attitudes and behaviours to improve the health care and well-being of children and families.
LEARN MOREHealthy Starts
The Healthy Starts Theme works to keep children and families healthy and out of the hospital by preventing lifelong health challenges and chronic diseases that are rooted in early childhood. We are passionate about furthering research into how a child’s family life and environment impact their health.
LEARN MOREDonate to Research
With your support, we believe there’s nothing we can’t do. Funding helps bring hope out of the laboratory and into the clinic — to save and improve children’s lives.
DONATE NOW